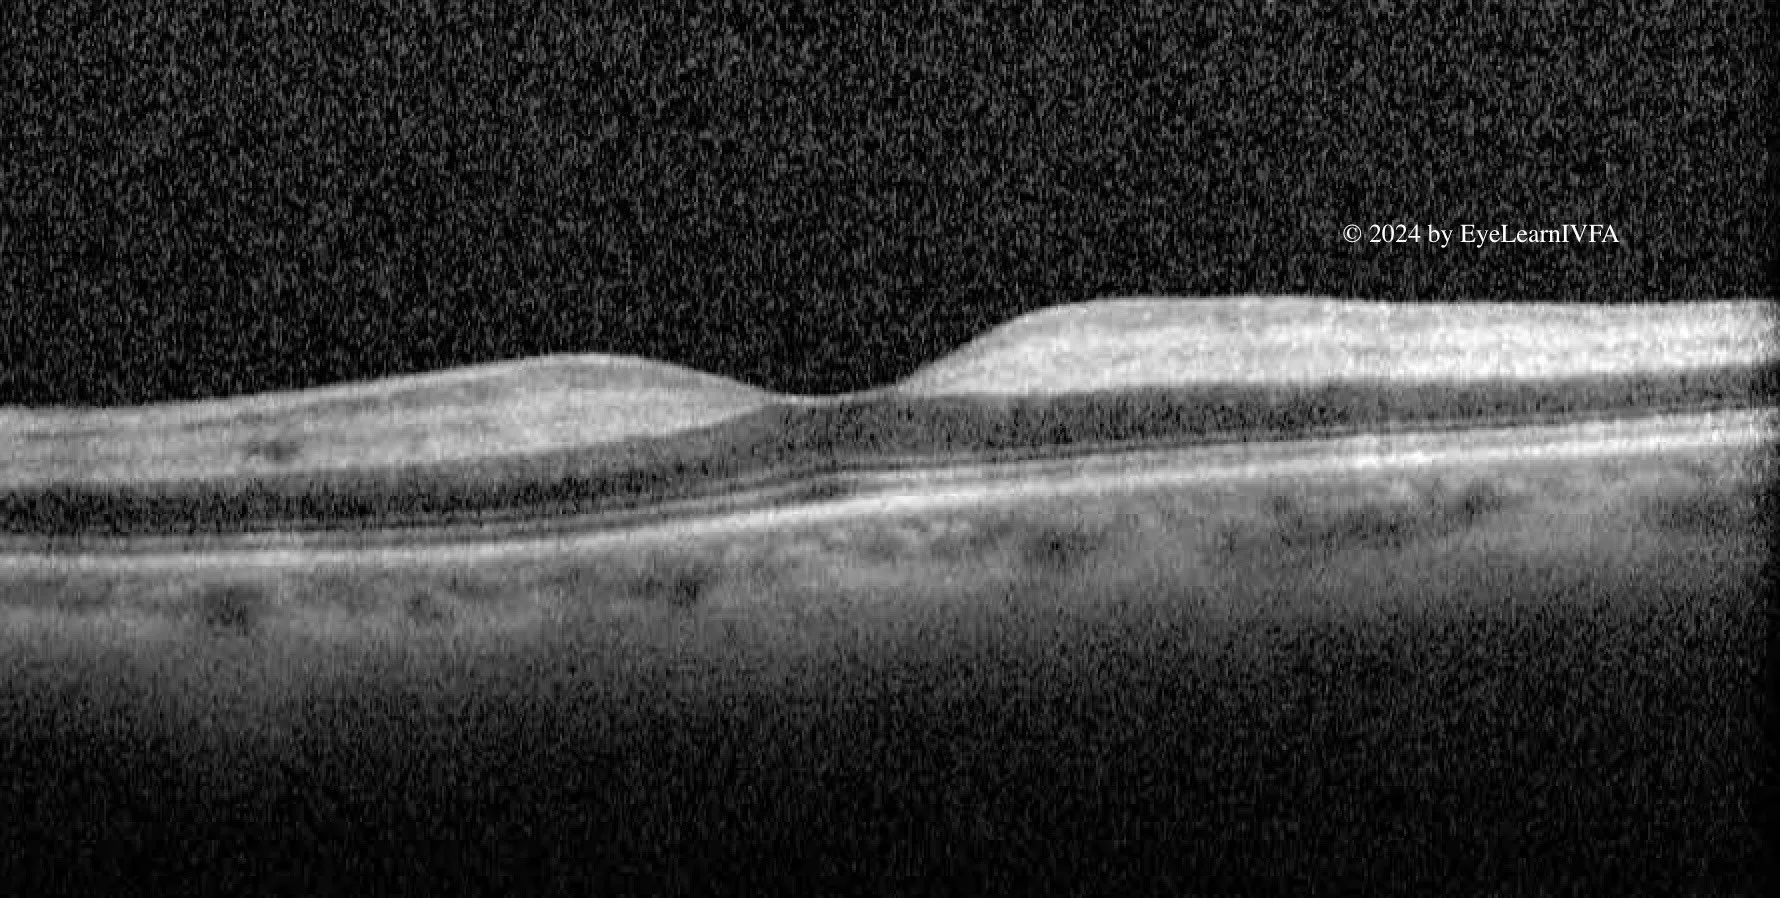

Neuro-Ophthalmology Case #1
Authors: Paige Campbell (1), Dr. Imran Jivraj (1), Dr. Alex Kaplan (2)
Affiliations: (1) University of Alberta (2) University of Toronto
ID: 72M; sudden vision loss OS with 1 month history of jaw pain.
Past Ocular History:
Pseudophakic OU
Ocular gtts: None
Relevant Medical History:
Hypertension
Normal CTA head and neck with minimal carotid disease 3 weeks prior
ESR 110, CRP 98
Medications: Amlodipine

-
IVFA at 22 seconds
Choroidal Phase.
Key features:
Patchy, delayed filling of the choroid with prominent nasal ischemia.
-
IVFA at 26 seconds
Arterial phase
Continued and more prominent patchy, incomplete — mottled background choroidal fluorescence with nasal choroidal ischemia (wedge like pattern)
Delayed and incomplete optic nerve head perfusion
Prolonged ateriovenous transit time (incomplete arterial filling at 26 seconds)
There is only one hyperfluoresent vessel. This is showing filling of a cilioretinal artery. It represents an anatomical variant of the posterior ciliary circulation, only present in 15-30% of the population. The artery fills early/first because it usually arises from the posterior ciliary arteries (choroidal circulation), rather than the central retinal artery.
-
IVFA at 33 seconds
Early Arterio-Venous Phase with Laminar Flow
Continued mottled background of choroidal fluorescence with nasal choroidal ischemia (wedge like pattern)
Prolonged ateriovenous transit time (33 seconds with incomplete arterio-venous filling)
-
IVFA at 2 minutes
Late Arteriovenous Phase
Although there was evidence of choroidal ischemia, retinal arterial filling is complete, but remarkably slow.
No obvious emboli, plaque or arterio-venous obstruction.
Slight hyperfluoresence around the disc (physiologic versus inflammatory)
-
The diagnosis is arteritic anterior ischemic optic neuropathy (AAION) secondary to giant cell arteritis (GCA). IVFA shows delayed choroidal filling with prolonged arteriovenous filling - a hallmark of posterior ciliary artery ischemia in GCA. These findings, combined with sudden vision loss, proceeding jaw pain, elevated inflammatory serological markers, a hyper-reflective OCT and subtle cherry red spot on clinical examination all point towards AAION related to giant cell arteritis.
-
The differential diagnosis for AAION with delayed choroidal filling on IVFA includes:
Severe Central Retinal Artery Occlusion (CRAO) — may rarely show delayed choroidal filling if ciliary circulation is affected
Ophthalmic Artery Occlusion — leads to both retinal and choroidal nonperfusion.
Hypotensive Ischemic Optic Neuropathy — peri-operative or shock-related, usually bilateral
Embolic Posterior Ciliary Artery Occlusion — less common, often sectoral
-
Confirm choroidal hypoperfusion, a hallmark of arteritic anterior ischemic optic neuropathy (AAION)
Assess for other causes of vision loss, such as central retinal artery occlusion or retinal vasculitis
Support the clinical suspicion of GCA in a patient with acute vision loss and systemic symptoms, aiding prompt and time sensitive treatment decision with intravenous steroids.
-
Hayreh SS. Giant cell arteritis: Its ophthalmic manifestations. Indian J Ophthalmol. 2021 Feb;69(2):227-235. doi:10.4103/ijo.IJO_1681_2012.
Vodopivec I, Rizzo JF. Ophthalmic manifestations of giant cell arteritis. Rheumatology (Oxford). 2018 Feb 1;57(suppl_2):ii63-ii72. doi:10.1093/rheumatology/kex428345.
Yu E, Chang JR. Giant Cell Arteritis: Updates and Controversies. Front Ophthalmol. 2022 Mar 17;2:848861. doi:10.3389/fopht.2022.848861